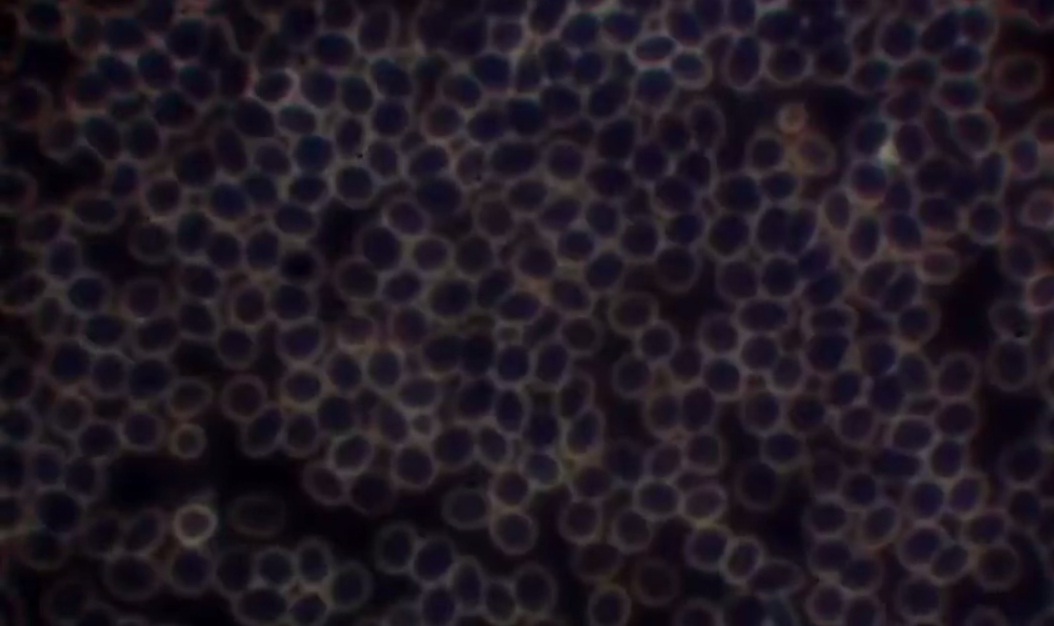

ENGL - ESP
<< >>
Coronavirus19 13ax4: Blutuntersuchung DUNKELFELDMIKROSKOPIE 01
Dunkelfeldmikroskopie - Dunkelfelddiagnostik - Blutanalyse unter dem Mikroskop
-- Liste der Heilmethoden gegen Corona19 (medizinische Lebensmittel, Weihrauch, Plasma, falsche Heilmittel, nie impfen, Orte der Ansteckungen etc. - Liste Link)
-- Beste Prävention oder Heilmittel gegen eine Grippe ist medizinische Ernährung+Blutgruppenernährung+früh schlafengehen+Natron mit Apfelessig (Link)
-- Vorerkrankungen heilen meist mit Natron weg (Merkblatt Natron)
Meldungen
präsentiert von Michael Palomino
| Teilen / share: |
Facebook |
|
Twitter
|
|
|
|
Blutuntersuchung mit Dunkelfeldmikroskop 17.12.2021 in Basel Frau Dr. Müller - Greifengasse 9 - 078-408 43 92
Impfschäden Schweiz Coronaimpfung, [17/12/2021 08:48 A.M.]
https://t.me/Impfschaden_Corona_Schweiz/34543
Dunkelfeldmikroskopie in Basel
Hallo Mara,
gestern habe ich etwas recherchiert: In Basel kann man das Blut unter dem Mikroskop untersuchen lassen, ob das Blut noch gesund ist oder von der GENimpfung "zerknittert" ist:
Dr. Andrea Müller - Greifengasse 9 - 4058 Basel (Kleinbasel gleich bei der Mittleren Rheinbrücke)
Webseite mit dem Thema Blut unter dem Mikroskop: https://naturalhealth-basel.ch/dunkelfeldmikroskopie/
Tel. 078-408 43 92 (man muss aufs Band sprechen) - E-Mail: kontakt@naturalhealth-basel.ch
Webseite mit Kontaktformular: https://naturalhealth-basel.ch/contact/
Sie sagte mir: 85 Franken
Und nun sollten sich wirklich alle Gimpften das Blut untersuchen lassen, um zu wissen, ob sie mit einer Fake-Impfung Glück gehabt haben oder nicht.
Gruss an alle und vielen Dank für eure Arbeit. Michael Palomino - www.med-etc.com
Blutuntersuchung mit Dunkelfeldmikroskop 17.12.2021: Webseite mit Naturheilpraktikern, wo man sich in der Schweiz testen lassen kann
Impfschäden Schweiz Coronaimpfung, [17/12/2021 04:18 P.M.]
https://t.me/Impfschaden_Corona_Schweiz/34613
Hallo Mara,
Hier ist eine neue Webseite mit Orten, wo man das Blut unter dem Dunkelmikroskop untersuchen kann, ob es geschädigt ist oder intakt ist:
http://www.med-etc.com/med/coronavirus/Dt/006bx004-orte-sich-testen-lassen-blut-dunkelfeldmikroskopie-CH-001.html
Das ist ein Anfang ohne Anspruch auf Vollständigkeit.
Synlab in Basel hatte ich heute telefonisch am Draht, die wussten von der Blutuntersuchung als Dunkelmikroskopie noch nichts.
Kommt alles noch hoffentlich. Die Gegenbewegung gegen die korrupten Bill-Gates-Regierungen ist am Laufen.
Gruss an alle und danke für eure Arbeit - Michael Palomino aus BS
Auf einer Webseite stand, dass die Zusatzversicherung diese Blutuntersuchung übernimmt. Die Grundversicherung nicht.
Blutuntersuchung mit Dunkelfeldmikroskop 17.12.2021: Webseite mit Naturheilpraktikern, wo man sich in der Schweiz testen lassen kann [37]
GENimpfschaden Blutbild unter dem Mikroskop kontrollieren 12.1.2022: VOR der GENimpfung und NACH der GENimpfung
Impfschäden Schweiz Coronaimpfung, [12/01/2022 09:12 P.M.]
https://t.me/Impfschaden_Corona_Schweiz/37005
[Antwort auf Impfschäden Schweiz Coronaimpfung]
Eine Meldung dazu:
Prof. Bakhdi hat dazu einen wichtigen Tipp gegeben. Wer sich impfen lassen will soll 2 Wochen vor der Impfung sein Blutbild kontrollieren lassen und das gleiche nach der Impfung nochmal. Scheinbar kann man sehen wie sehr es sich danach verändert/verdickt..
Medizinisches: Gesundes Blut 17.2.2022: Alle Blutkörperchen sind beweglich
Impfschäden Schweiz Coronaimpfung, [17/02/2022 03:28 P.M.]
[Weitergeleitet aus COVID VACCINE VICTIMS AND FAMILIES]
Video-Link: https://t.me/Impfschaden_Corona_Schweiz/39584
Video auf Bitchute: https://www.bitchute.com/video/nigeMtI0PHdr/
Medizinisches: Gesundes Blut 17.2.2022: Alle Blutkörperchen sind beweglich [56]
Video 17.2.2022: Gesundes Blut - healthy blood - sangre sana - sang sain - gezond bloed (1'25'')
Video 17.2.2022: Gesundes Blut - healthy blood - sangre sana - sang sain - gezond bloed (1'25'')
https://www.bitchute.com/video/nigeMtI0PHdr/ - Bitchute-Kanal: NatMed-etc. - hochgeladen am 18.2.2022
Blood of unvaccinated people.
@Covid19VaccineVictims
Medizinisches: Kaputtes Blut von GENgeimpften 17.2.2022: alle Blutkörperchen sind gestapelt
Impfschäden Schweiz Coronaimpfung, [17/02/2022 03:28 P.M.]
[Weitergeleitet aus COVID VACCINE VICTIMS AND FAMILIES]
Video-Link: https://t.me/Impfschaden_Corona_Schweiz/39585
Video auf Bitchute: https://www.bitchute.com/video/hAmqcb7IF66I/
Blood sample of double vaccinated. She was so shocked and she cancelled her booster appointment.Video 17.2.2022: Blut von GENgeimpften gestapelt - blood of vaxxed piled up - sangre de vacunados en pilas (1'23'')
Video 17.2.2022: Blut von GENgeimpften gestapelt - blood of vaxxed piled up - sangre de vacunados en pilas (1'23'')
https://www.bitchute.com/video/hAmqcb7IF66I/ - Bitchute-Kanal: NatMed-etc. - hochgeladen am 18.2.2022
@Covid19VaccineVictims
Medizinisches: Kaputtes Blut von GENgeimpften 17.2.2022: Das Blut ist voller Bakterien und Parasiten
Impfschäden Schweiz Coronaimpfung, [17/02/2022 03:28 P.M.]
[Weitergeleitet aus COVID VACCINE VICTIMS AND FAMILIES]
Video-Link: https://t.me/Impfschaden_Corona_Schweiz/39586
Video auf Bitchute: https://www.bitchute.com/video/K40JZQFZskob/
Medizinisches: Kaputtes Blut von GENgeimpften 17.2.2022: Das Blut ist voller Bakterien und Parasiten [58]
Aside from this I also see visibly infected lymphocytes + That scares me as it could indicate severe corruption of the immune system in a way that I have never seen before. According to Luc Montagnier everyone who = 3x jabbed should get a HIV test i think he's right. Source of this video (https://twitter.com/Euniqueje/status/1494008549822930950?t=U6VJ6d_wqOHyRQl0gGsyyw&s=19)Video 17.2.2022: Blut von GENgeimpften Bakterien+Parasiten - blood of vaxxed bacteria+parasites (2'13'')
Video 17.2.2022: Blut von GENgeimpften Bakterien+Parasiten - blood of vaxxed bacteria+parasites (2'13'')
https://www.bitchute.com/video/K40JZQFZskob/ - Bitchute-Kanal: NatMed-etc. - hochgeladen am 18.2.2022
@Covid19VaccineVictims
<< >>
| Teilen / share: |
Facebook |
|
Twitter
|
|
|
|
Quellen
Fotoquellen
[1] https://vk.com/fritz1956#/fritz1956?z=photo463459746_457254737%2Fwall417878056_72367






















^